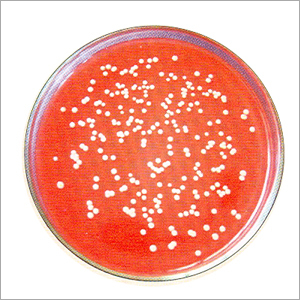
Macconkey Agar

Macconkey Agar
Price:
Get Latest Price
In Stock
Product Specifications
| Color | Red |
| Diameter | 150mm |
| Features | Bacterial growth, Selective media, Easy to use, Reliable results, Cost-effective, High quality |
| Material | Agar agar |
| PH | 7.1-7.4 |
| Shelf life | 1 year |
| Sterility | Sterile |
| Storage | Refrigerated |
Company Details
Established in 2000, ANMOL SCIENTIFIC TRADERS has made a name for itself in the list of top suppliers of Lab Chemicals & Supplies in India. The supplier company is located in Kurukshetra, Haryana, and is one of the leading sellers of listed products.
ANMOL SCIENTIFIC TRADERS is listed in Trade India's list of verified sellers offering supreme quality of Lactose Broth, Macconkey Agar, Prepared Slides, etc. Buy Lab Chemicals & Supplies in bulk from us for the best quality products and service.
ANMOL SCIENTIFIC TRADERS is listed in Trade India's list of verified sellers offering supreme quality of Lactose Broth, Macconkey Agar, Prepared Slides, etc. Buy Lab Chemicals & Supplies in bulk from us for the best quality products and service.
Business Type
Manufacturer, Supplier
Establishment
2000
Working Days
To
Related Products
Explore Related Categories
More Products From This Seller
Seller Details
Kurukshetra, Haryana
Proprietor
Mr. Sunil Dahiya
Address
Shop No 21, Jat Dharamshala, Kurukshetra, Haryana, 133001, India
Report incorrect details
























